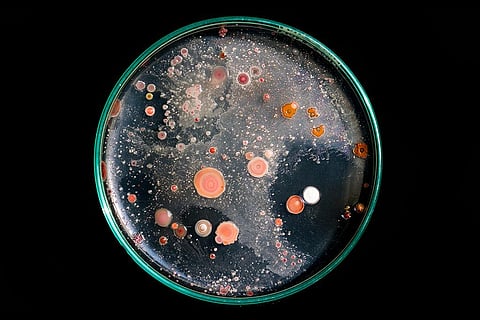

इसमें कोई शक नहीं कि सूक्ष्म जीव धरती के पारिस्थितिक तंत्र में महत्वपूर्ण भूमिका निभाते हैं, लेकिन क्या आप जानते हैं कि इनकी भूमिका बढ़ते तापमान के साथ बदल रही हैं। वैज्ञानिकों ने इस बात का तो पता लगा लिया है कि कैसे वायरस अधिकांश प्रकार के सूक्ष्मजीवों को संक्रमित कर सकते हैं, लेकिन उन्हें अभी भी इस बारे में बहुत सीमित जानकारी है कि कैसे इस तरह के वायरल संक्रमण बढ़ते तापमान पर रोगाणुओं की प्रतिक्रिया को बदल सकते हैं।
देखा जाए तो इकोसिस्टम में ऊर्जा और तत्व कैसे प्रवाहित होते हैं, जलवायु परिवर्तन उन्हें प्रभावित कर रहा है। ऐसे में उनपर पड़ने वाले इन प्रभावों के चलते वैश्विक रूप से कार्बन और पोषक चक्र भी प्रभावित हो रहा है। चूंकि यह सूक्ष्मजीव कार्बन और पोषक तत्वों के इस चक्रण में अहम भूमिका निभाते हैं। ऐसे में वो पारिस्थितिक तंत्र और जलवायु के बीच की एक अभिन्न कड़ी हैं।
जर्नल एफईएमएस माइक्रोबायोलॉजी इकोलॉजी में प्रकाशित रिसर्च में इस बारे में जानकारी दी गई है कि किस तरह से बढ़ते तापमान से वायरस और उनके माइक्रोबियल होस्ट प्रभावित हो सकते हैं। शोधकर्ताओं का मानना है कि यह बदलाव इस बात को प्रभावित कर सकते हैं कि कैसे पूरा पारिस्थितिक तंत्र बढ़ते तापमान के प्रति प्रतिक्रिया करता है।
इस अध्ययन के बारे में वैज्ञानिकों का कहना है कि यह रिसर्च ग्लोबल वार्मिंग, वायरस और पारिस्थितिकी तंत्र के कामकाज के बीच के संबंधों को उजागर करती है। वैज्ञानिकों के मुताबिक यह अध्ययन उन अलग-अलग तरीकों को समझने के लिए रोडमैप प्रस्तुत करता है, जिनकी मदद से वायरस, सूक्ष्मजीवों पर पड़ने वाले ग्लोबल वार्मिंग के प्रभावों को पलट सकते हैं।
क्या कुछ निकलकर आया अध्ययन में सामने
रिसर्च के मुताबिक यह वायरस, सूक्ष्मजीवों से संबंधित प्रक्रियाओं और पारिस्थितिक तंत्र के कामकाज पर गहरा प्रभाव डाल सकते हैं। ऐसे में पारिस्थितिक तंत्र संबंधी मॉडल में इनके प्रभावों को शामिल करने से जिन्हें पहले नजरअंदाज कर दिया गया था, वैज्ञानिकों को इस बाते की भविष्यवाणी में सुधार करने में मदद मिलेगी कि कैसे पारिस्थितिकी तंत्र, जलवायु परिवर्तन के खिलाफ प्रतिक्रिया कर सकता है।
देखा जाए तो यह सूक्ष्मजीव, प्रकाश संश्लेषण (कार्बन अपटेक), श्वसन (कार्बन रिलीज), और अपघटन (यानी कार्बन रीसाइक्लिंग) जैसी प्रक्रियाओं के माध्यम से ऊर्जा और पदार्थ के प्रवाह को नियंत्रित करके पारिस्थितिक तंत्र में महत्वपूर्ण भूमिका निभाते हैं।
वर्तमान में पारिस्थितिक तंत्र कैसे कार्य करते हैं, जलवायु परिवर्तन उसमें बदलाव कर रहा है। इसके लिए वो सूक्ष्म जीवों के आहार जाल में जीव कैसे भूमिका निभाते हैं, उनके तरीकों में भी फेर-बदल कर रहा है।
वैज्ञानिकों को पहले से ही ज्ञात है कि वायरस माइक्रोबियल प्रक्रियाओं पर गहरा प्रभाव डाल सकते हैं, लेकिन इस बात की बहुत कम जानकारी उपलब्ध है कि भविष्य में बढ़ते तापमान के साथ यह प्रभाव किस तरह बदल जाएंगे। रिसर्च के मुताबिक संभावित रूप से बढ़ता तापमान वायरस संक्रमण चक्र के कई अलग-अलग चरणों को प्रभावित करता है। साथ ही वो वायरस और उसके होस्ट के बीच की गतिशीलता को भी प्रभावित कर सकता है।
चूंकि वायरस हर तरह के वातावरण में जीवित रहने के काबिल है और साथ ही सूक्ष्म जीवों की कार्यप्रणाली पर गहरा प्रभाव डालता है। ऐसे में यह समझना जरूरी है कि कैसे बढ़ता तापमान किसी इकोसिस्टम के भीतर ऊर्जा और तत्त्व के प्रवाह को प्रभावित करेगा।
वैज्ञानिकों के मुताबिक प्रारंभिक मॉडल बताते हैं कि वायरस संभावित रूप से प्राकृतिक कार्बन संतुलन में फेर-बदल कर सकते हैं। इसकी वजह से वो पारिस्थितिक तंत्र जो पहले कार्बन के शुद्ध स्रोत थे, मतलब भण्डारण की तुलना में कहीं ज्यादा कार्बन उत्सर्जित कर रहे थे, वो आने वाले समय में शुद्ध कार्बन सिंक में बदल सकते हैं। मतलब की वो कार्बन मुक्त करने की जगह उसे सोखना शुरू कर देंगें।
ऐसे में वैज्ञानिकों का कहना है कि यदि हम जलवायु परिवर्तन और पारिस्थितिक तंत्र के बारे में अपनी भविष्यवाणियों में वायरस को भी शामिल करते हैं, तो हम नए और आश्चर्यजनक प्रभावों की खोज कर सकते हैं।